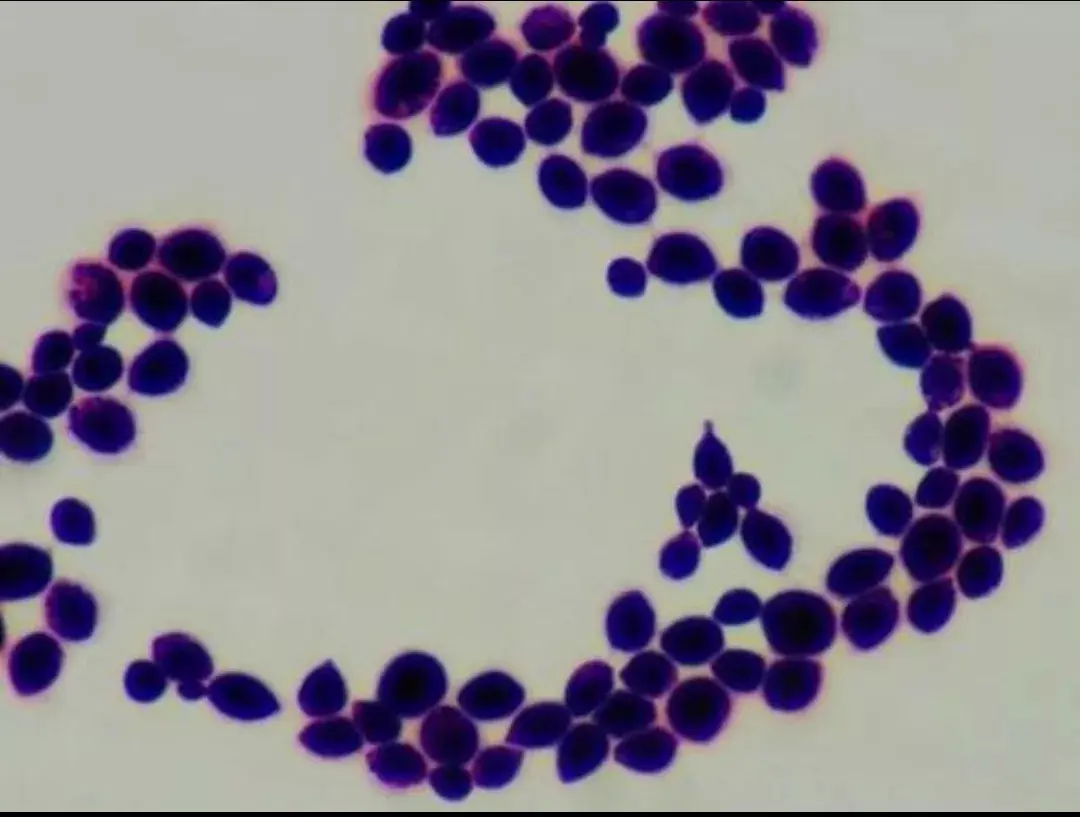

真菌这东西太“分裂”了:既能是餐桌上鲜美的香菇、松茸,也能变成夺人性命的隐形杀手。
《柳叶刀・传染病》最新数据扎了心:全球每年有375万人死于真菌感染,算下来每分钟就有7人因此丧生。
其中最狠的要数隐球菌,这玩意儿能突破人血脑屏障引发脑膜炎,致死率高达40%。更让人揪心的是,40年前这类致死病例少之又少,如今却越来越常见。
就在这危急关头,中国科学院微生物研究所王琳淇团队的研究,给无数患者撬开了生的缝隙。
为啥致命真菌感染突然“冒头”?科学家揪出了两大元凶。
首先是全球变暖在“帮凶”:人体37℃的体温本是天然防线,多数真菌耐不住这温度。可气候变暖逼着一些特殊真菌进化出耐高温能力,突破体温屏障后,就能轻松入侵人体。
另一个关键是易感人群越来越多:全球4000多万艾滋病患者里,20%到25%的死亡都和真菌感染有关;癌症患者、器官移植患者这些免疫缺陷人群,更是高危群体。
咱们国家老龄人口已占20%,老年人免疫力弱,也成了真菌攻击的重点目标。双重因素叠加,让真菌感染从“罕见病”变成了不容忽视的健康威胁。
王琳淇团队的突破,是从患者的绝境里“逼”出来的。回国后他常和医生交流,一位医生的话让他彻夜难眠。
隐球菌脑膜炎治疗要半年到几年,好多患者掏不起钱只能放弃,随访时电话再也打不通。这份沉重让他下定决心攻克难题。
团队先发现一个关键线索:脑部的葡萄糖居然会直接驱动隐球菌产生耐药性。可葡萄糖到底怎么让真菌“刀枪不入”?
隐球菌
他们推测有未知耐药分子在作祟,可找起来比大海捞针还难。
研究陷入僵局时,王琳淇担心学生陈磊毕不了业,提出给个“PlanB”,没想到陈磊硬气回怼:“我只要PlanA,宁要伟大的失败,不要廉价的成功”。
这份执拗没白费,团队最终锁定关键机制,还找到了潜在治疗突破口,给耐药难题开了药方。
这突破的意义,远不止救了病人。对患者来说,它意味着不用再被漫长治疗和高昂费用逼到绝路,意味着那些曾打不通的随访电话,未来可能传来康复的消息。
对科研界而言,陈磊“不要PlanB”的倔强,正是中国科研人“啃硬骨头”精神的缩影,如今陈磊已带起自己的团队,这份坚守正在传承。
王琳淇常说,好的科研要“能让自己铭记一生”,把个人兴趣和国家需求绑在一起才最幸福。在真菌仍有90%以上未被探索的当下,这份坚持太重要了。
从实验室里的无数次失败,到临床中可能挽救的生命,中国科学家用行动证明:所谓奇迹,不过是有人敢啃硬骨头、敢为生命拼到底。
而这,正是我们面对未知疾病时最踏实的底气。